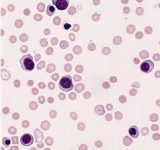

-
●退職早い!殺人バファローニートにマッマ仰天
投稿日 2019年2月20日 02:08:00 (スポーツ)
-
巨人小笠原、白血病を公開し死亡
投稿日 2019年2月20日 01:08:00 (スポーツ)
-
息子に七七七(あたる)って名付けたいんやが
投稿日 2019年2月19日 23:21:00 (スポーツ)
-
淫夢語録で上司との呑みが上手くいくことが判明!
投稿日 2019年2月19日 22:22:00 (スポーツ)
-
【悲報】サンフレッチェ広島、ACLプレーオフで苦戦してしまう
投稿日 2019年2月19日 22:07:00 (スポーツ)
-
「電車を止めたかったでやんす」線路に発炎筒 パワフル高校1年生の少年を逮捕
投稿日 2019年2月19日 21:33:00 (スポーツ)
-
鹿島、4発快勝でACLプレーオフを勝ち上がり本戦出場決定!3年連続9回目
投稿日 2019年2月19日 21:22:17 (スポーツ)
-
ワイ紅しょうが大臣、牛丼屋の紅しょうが有償化案を提出
投稿日 2019年2月19日 20:57:00 (スポーツ)
-
ワイ「最近身体おかしいなぁ」肝臓「……」
投稿日 2019年2月19日 19:55:00 (スポーツ)
-
さけるグミのCMとかいうCM業界久々のヤバイ奴www
投稿日 2019年2月19日 18:13:00 (スポーツ)
-
【悲報】日本とスペイン、同じパスサッカー国でもプレーが全然違っていた
投稿日 2019年2月19日 17:30:36 (スポーツ)
-
彡(^)(^)「長髪を活かしてギターになったろ!」
投稿日 2019年2月19日 17:23:00 (スポーツ)
-
30代女優で打線組んだwwwwwwwwwwwwwww
投稿日 2019年2月19日 16:38:00 (スポーツ)
-
女騎士「くっ…何を飲ませた」彡(゚)(゚)「ククク…」
投稿日 2019年2月19日 15:55:00 (スポーツ)
-
淫夢語録だけで上司や取引先のご機嫌がとれると判明
投稿日 2019年2月19日 14:56:00 (スポーツ)
-
【悲報】自由が丘の中華料理屋の語彙力wwwwwwwww
投稿日 2019年2月19日 13:40:00 (スポーツ)
-
女「あの、ご趣味は?」ワイ「ロングコートの中で屁をこき、自分の屁を嗅ぐことです」
投稿日 2019年2月19日 12:49:00 (スポーツ)
-
お前らが"サッカー選手とバレンティン意外"で知ってるオランダ人っているの?
投稿日 2019年2月19日 11:30:09 (スポーツ)
-
ごま油とかいう有能調味料
投稿日 2019年2月19日 09:25:00 (スポーツ)
-
(o‘ω‘n)発射準備よおおおい
投稿日 2019年2月19日 08:53:00 (スポーツ)
-
イニエスタ「日本人最高や!負けても喝采を送ってくれる!」
投稿日 2019年2月19日 08:30:33 (スポーツ)
-
総資産15兆円のAmazon創設者ジェフベゾスがハゲているという事実
投稿日 2019年2月19日 07:08:00 (スポーツ)
-
ルフィ「だってよ………syamuクス………!!!!」
投稿日 2019年2月19日 06:08:00 (スポーツ)
-
隣の部屋から「エイシャ!」って聞こえてくるんやが・・・
投稿日 2019年2月19日 05:08:00 (スポーツ)
-
【悲報】織田信長さん、明智光秀へのパワハラが発覚して大炎上
投稿日 2019年2月19日 04:08:00 (スポーツ)
-
彡(^)(^)「サンガツ超えてシガツやんけ!」
投稿日 2019年2月19日 02:08:00 (スポーツ)
-
俺「からあげくん、nanacoで」 店員「七個ですね(カラアゲドサー
投稿日 2019年2月19日 01:08:00 (スポーツ)
-
彡(゚)(゚)「アマで解説囓(かじ)ってる」
投稿日 2019年2月19日 00:08:00 (スポーツ)
-
【画像-】カスタネット、カスタネットじゃなかった
投稿日 2019年2月18日 23:08:00 (スポーツ)
-
リアルなハムスターを育成できるアプリが登場!🐹
投稿日 2019年2月18日 22:08:00 (スポーツ)